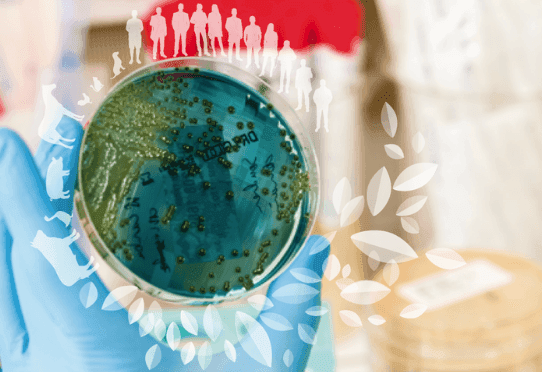
Description de l'image

Le 12 mars 2024
Modifié le 13 novembre 2024
L’interface nationale Antibiorésistance a pour ambition de rendre visible la recherche française autour de l’antibiorésistance, de permettre l’accès à l’ensemble des recherches et informations portées par les alliances de recherche (AllEnvi, Aviesan et Athena), les organismes et instituts de recherche incluant leurs laboratoires et leurs plateformes, les structures et infrastructures financées dans le cadre du Programme d’Investissements d’Avenir, les agences de financement, les actions européennes et internationales, les acteurs du monde industriel (industriels et start-ups), les syndicats des industriels de la santé, sur les essais cliniques et de faciliter et d’assurer la continuité et le partage d’informations émises par les ministères et Santé publique France en charge de la surveillance.
En trois points, il s’agit :